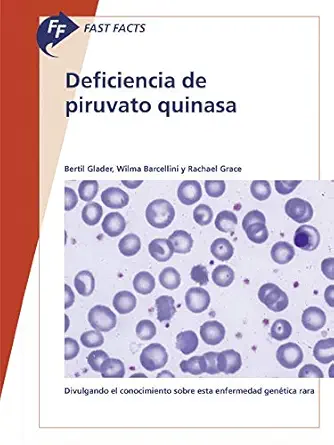

By Bertil Glader, Wilma Barcellini, Rachael Grace Es posible que no esté familiarizado con la deficiencia de piruvato quinasa (PK). Se trata de un raro trastorno enzimático heredado que afecta a la ruta glicolítica utilizada por los glóbulos rojos para producir energía, y que se manifiesta como una anemia hemolítica. Los síntomas verían mucho entre las personas, lo que dificulta el diagnóstico. La atención primaria se compone fundamentalmente de tratamientos de apoyo. Escrito por expertos en el ámbito, ‘Fast Facts: deficiencia de piruvato quinasa’ proporciona una completa introducción sobre la enfermedad y explica: • el defecto subyacente • su transmisión hereditaria y la relación entre el genotipo y el fenotipo • la manifestación de la enfermedad • los fundamentos del diagnóstico y cómo diferenciar la enfermedad de un grupo heterogéneo de trastornos hemolíticos • el control y el manejo de las complicaciones que pueden surgir. ‘Fast Facts: deficiencia de piruvato quinasa’ es una obra de interés para médicos de familia, hematólogos, oncólogos, pediatras, internistas, enfermeras de hematología y estudiantes de medicina; además de para todos los que quieran saber más acerca de este raro trastorno genético de la sangre.
Product Details
ASIN : B085Z78B7D
Publisher : S. Karger; 1st edition (September 30, 2019)
Publication date : September 30, 2019
Language : Spanish
Screen Reader : Supported

Reviews
There are no reviews yet.